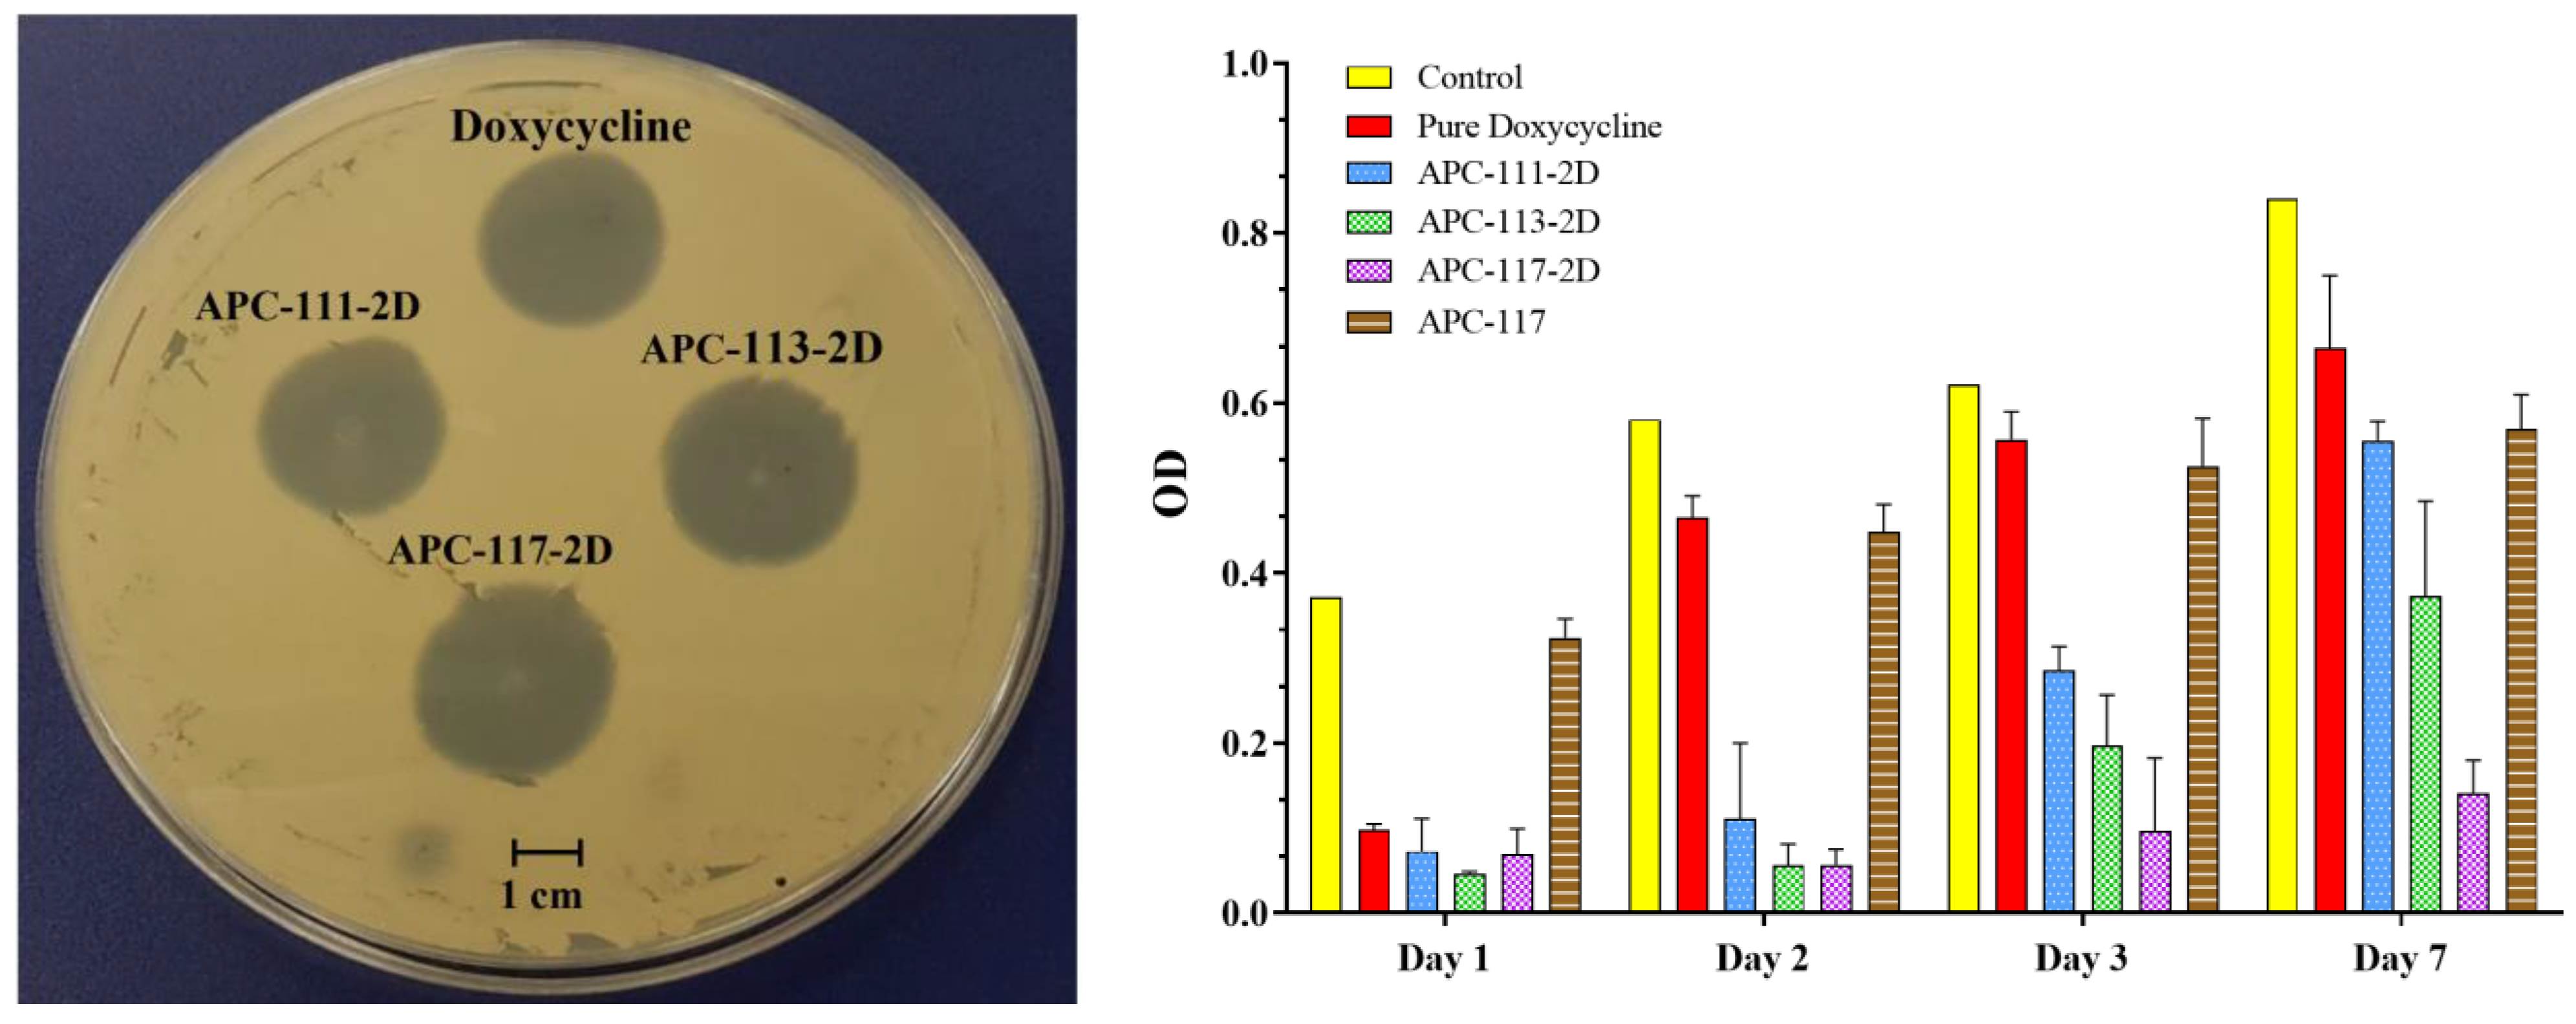

A Novel Three-Polysaccharide Blend In Situ Gelling Powder for Wound Healing Applications
Abstract
:1. Introduction
2. Materials and Methods
2.1. Powders Preparation
2.1.1. Alginate/Pectin and Doxycycline Powders
2.1.2. Alginate/Pectin/Chitosan, and Doxycycline Powders
2.2. Drug Content and Encapsulation Efficiency
2.3. Powders Characterization
2.3.1. Morphology and Particle Size Distribution
2.3.2. Fluid Uptake Ability
2.3.3. Fourier Transform Infrared Spectroscopy (FT-IR)
2.4. In Vitro Drug Release
2.5. Rheological Studies
2.6. Antimicrobial Assay
2.7. In Vitro Test
2.7.1. Cell Culture Conditions for MTT and ELISA Assay
2.7.2. MTT Assay
2.7.3. ELISA Assay
2.7.4. Cell Culture and Treatments for Zymography
2.7.5. SDS-PAGE Gelatin Zymography
3. Results and Discussion
3.1. Preparation and Characterization of the Powders
3.2. In Vitro Drug Release
3.3. Powders Antimicrobial Activity
3.4. In Vitro Test
3.4.1. MTT and ELISA Assay
3.4.2. SDS-PAGE Gelatin Zymography
4. Conclusions
5. Patents
Supplementary Materials
Author Contributions
Funding
Institutional Review Board Statement
Conflicts of Interest
References
- Bowling, F.L.; Rashid, S.T.; Boulton, A.J.M. Preventing and treating foot complications associated with diabetes mellitus. Nat. Rev. Endocrinol. 2015, 11, 606–616. [Google Scholar] [CrossRef] [PubMed]
- Sun, B.K.; Siprashvili, Z.; Khavari, P.A. Advances in skin grafting and treatment of cutaneous wounds. Science 2014, 346, 941–945. [Google Scholar] [CrossRef]
- Sgonc, R.; Sgonc, R.; Gruber, J. Age-Related Aspects of Cutaneous Wound Healing: A Mini-Review. Gerontology 2013, 59, 159–164. [Google Scholar] [CrossRef]
- Järbrink, K.; Ni, G.; Sönnergren, H.; Schmidtchen, A.; Pang, C.; Bajpai, R.; Car, J. Prevalence and incidence of chronic wounds and related complications: A protocol for a systematic review. Syst. Rev. 2016, 5, 152. [Google Scholar] [CrossRef] [PubMed] [Green Version]
- Yang, X.; Yang, J.; Wang, L.; Ran, B.; Jia, Y.; Zhang, L.; Yang, G.; Shao, H.; Jiang, X. Pharmaceutical Intermediate-Modified Gold Nanoparticles: Against Multidrug-Resistant Bacteria and Wound-Healing Application via an Electrospun Scaffold. ACS Nano 2017, 11, 5737–5745. [Google Scholar] [CrossRef] [PubMed]
- Sudheesh Kumar, P.T.; Lakshmanan, V.-K.; Anilkumar, T.V.; Ramya, C.; Reshmi, P.; Unnikrishnan, A.G.; Nair, S.V.; Jayakumar, R. Flexible and Microporous Chitosan Hydrogel/Nano ZnO Composite Bandages for Wound Dressing: In Vitro and In Vivo Evaluation. ACS Appl. Mater. Interfaces 2012, 4, 2618–2629. [Google Scholar] [CrossRef] [PubMed]
- Demidova-Rice, T.N.; Hamblin, M.R.; Herman, I.M.J.A. Acute and impaired wound healing: Pathophysiology and current methods for drug delivery, part 1: Normal and chronic wounds: Biology, causes, and approaches to care. Adv. Ski. Wound Care 2012, 25, 304. [Google Scholar] [CrossRef] [Green Version]
- Jeon, O.; Samorezov, J.E.; Alsberg, E. Single and dual crosslinked oxidized methacrylated alginate/PEG hydrogels for bioadhesive applications. Acta Biomater. 2014, 10, 47–55. [Google Scholar] [CrossRef] [Green Version]
- Ganesan, P. Natural and bio polymer curative films for wound dressing medical applications. Wound Med. 2017, 18, 33–40. [Google Scholar] [CrossRef]
- Huang, R.; Li, W.; Lv, X.; Lei, Z.; Bian, Y.; Deng, H.; Wang, H.; Li, J.; Li, X. Biomimetic LBL structured nanofibrous matrices assembled by chitosan/collagen for promoting wound healing. Biomaterials 2015, 53, 58–75. [Google Scholar] [CrossRef]
- Boateng, J.; Catanzano, O. Advanced Therapeutic Dressings for Effective Wound Healing—A Review. J. Pharm. Sci. 2015, 104, 3653–3680. [Google Scholar] [CrossRef] [Green Version]
- De Cicco, F.; Russo, P.; Reverchon, E.; García-González, C.A.; Aquino, R.P.; Del Gaudio, P. Prilling and supercritical drying: A successful duo to produce core-shell polysaccharide aerogel beads for wound healing. Carbohydr. Polym. 2016, 147, 482–489. [Google Scholar] [CrossRef]
- Dong, R.-H.; Jia, Y.-X.; Qin, C.-C.; Zhan, L.; Yan, X.; Cui, L.; Zhou, Y.; Jiang, X.; Long, Y.-Z. In situ deposition of a personalized nanofibrous dressing via a handy electrospinning device for skin wound care. Nanoscale 2016, 8, 3482–3488. [Google Scholar] [CrossRef] [PubMed]
- Liu, M.; Luo, G.; Wang, Y.; Xu, R.; Wang, Y.; He, W.; Tan, J.; Xing, M.; Wu, J. Nano-silver-decorated microfibrous eggshell membrane: Processing, cytotoxicity assessment and optimization, antibacterial activity and wound healing. Sci. Rep. 2017, 7, 436. [Google Scholar] [CrossRef] [PubMed] [Green Version]
- Rodríguez-Dorado, R.; López-Iglesias, C.; García-González, C.A.; Auriemma, G.; Aquino, R.P.; Del Gaudio, P. Design of Aerogels, Cryogels and Xerogels of Alginate: Effect of Molecular Weight, Gelation Conditions and Drying Method on Particles’ Micromeritics. Molecules 2019, 24, 1049. [Google Scholar] [CrossRef] [PubMed] [Green Version]
- Percival, S.L.; McCarty, S.; Hunt, J.A.; Woods, E.J. The effects of pH on wound healing, biofilms, and antimicrobial efficacy. Wound Repair Regen. 2014, 22, 174–186. [Google Scholar] [CrossRef] [PubMed]
- Domingos, M.O.; Franzolin, M.R.; dos Anjos, M.T.; Franzolin, T.M.P.; Barbosa Albes, R.C.; de Andrade, G.R.; Lopes, R.J.L.; Barbaro, K.C. The influence of environmental bacteria in freshwater stingray wound-healing. Toxicon 2011, 58, 147–153. [Google Scholar] [CrossRef]
- Eaglstein, W.H.; Davis, S.C.; Mehle, A.L.; Mertz, P.M. Optimal Use of an Occlusive Dressing to Enhance Healing: Effect of Delayed Application and Early Removal on Wound Healing. Arch. Dermatol. 1988, 124, 392–395. [Google Scholar] [CrossRef]
- Auriemma, G.; Russo, P.; Del Gaudio, P.; García-González, C.A.; Landín, M.; Aquino, R.P. Technologies and Formulation Design of Polysaccharide-Based Hydrogels for Drug Delivery. Molecules 2020, 25, 3156. [Google Scholar] [CrossRef]
- Aduba, D.C.; Yang, H. Polysaccharide Fabrication Platforms and Biocompatibility Assessment as Candidate Wound Dressing Materials. Bioengineering 2017, 4, 1. [Google Scholar] [CrossRef] [Green Version]
- Rabiee, T.; Yeganeh, H.; Gharibi, R.J.B.M. Antimicrobial wound dressings with high mechanical conformability prepared through thiol-yne click photopolymerization reaction. Biomed. Mater. 2019, 14, 045007. [Google Scholar] [CrossRef]
- Fulton, J.A.; Blasiole, K.N.; Cottingham, T.; Tornero, M.; Graves, M.; Smith, L.G.; Mirza, S.; Mostow, E.N. Wound Dressing Absorption: A Comparative Study. Adv. Ski. Wound Care 2012, 25, 315–320. [Google Scholar] [CrossRef]
- Tran, N.Q.; Joung, Y.K.; Lih, E.; Park, K.D. In Situ Forming and Rutin-Releasing Chitosan Hydrogels As Injectable Dressings for Dermal Wound Healing. Biomacromolecules 2011, 12, 2872–2880. [Google Scholar] [CrossRef]
- Wang, Y.; Wang, C.; Xie, Y.; Yang, Y.; Zheng, Y.; Meng, H.; He, W.; Qiao, K. Highly transparent, highly flexible composite membrane with multiple antimicrobial effects used for promoting wound healing. Carbohydr. Polym. 2019, 222, 114985. [Google Scholar] [CrossRef] [PubMed]
- Del Gaudio, P.; De Cicco, F.; Aquino, R.P.; Picerno, P.; Russo, P.; Dal Piaz, F.; Bizzarro, V.; Belvedere, R.; Parente, L.; Petrella, A. Evaluation of in situ injectable hydrogels as controlled release device for ANXA1 derived peptide in wound healing. Carbohydr. Polym. 2015, 115, 629–635. [Google Scholar] [CrossRef]
- Pal, K.; Banthia, A.; Majumdar, D.J.T.B.A.O. Preparation of transparent starch based hydrogel membrane with potential application as wound dressing. Trends Biomater. Artif. Organs 2006, 20, 59–67. [Google Scholar]
- De Cicco, F.; Reverchon, E.; Adami, R.; Auriemma, G.; Russo, P.; Calabrese, E.C.; Porta, A.; Aquino, R.P.; Del Gaudio, P. In situ forming antibacterial dextran blend hydrogel for wound dressing: SAA technology vs. spray drying. Carbohydr. Polym. 2014, 101, 1216–1224. [Google Scholar] [CrossRef]
- Balakrishnan, B.; Mohanty, M.; Umashankar, P.R.; Jayakrishnan, A. Evaluation of an in situ forming hydrogel wound dressing based on oxidized alginate and gelatin. Biomaterials 2005, 26, 6335–6342. [Google Scholar] [CrossRef] [PubMed]
- Wang, Q.; Hu, X.; Du, Y.; Kennedy, J.F. Alginate/starch blend fibers and their properties for drug controlled release. Carbohydr. Polym. 2010, 82, 842–847. [Google Scholar] [CrossRef]
- Dong, Z.; Wang, Q.; Du, Y. Alginate/gelatin blend films and their properties for drug controlled release. J. Membr. Sci. 2006, 280, 37–44. [Google Scholar] [CrossRef]
- Thomas, A.; Harding, K.G.; Moore, K. Alginates from wound dressings activate human macrophages to secrete tumour necrosis factor-α. Biomaterials 2000, 21, 1797–1802. [Google Scholar] [CrossRef]
- De Cicco, F.; Porta, A.; Sansone, F.; Aquino, R.P.; Del Gaudio, P. Nanospray technology for an in situ gelling nanoparticulate powder as a wound dressing. Int. J. Pharm. 2014, 473, 30–37. [Google Scholar] [CrossRef] [PubMed]
- Rathke, T.D.; Hudson, S.M. Review of Chitin and Chitosan as Fiber and Film Formers. J. Macromol. Sci. Part C 1994, 34, 375–437. [Google Scholar] [CrossRef]
- Romić, M.D.; Klarić, M.Š.; Lovrić, J.; Pepić, I.; Cetina-Čižmek, B.; Filipović-Grčić, J.; Hafner, A. Melatonin-loaded chitosan/Pluronic® F127 microspheres as in situ forming hydrogel: An innovative antimicrobial wound dressing. Eur. J. Pharm. Biopharm. 2016, 107, 67–79. [Google Scholar] [CrossRef]
- Koosehgol, S.; Ebrahimian-Hosseinabadi, M.; Alizadeh, M.; Zamanian, A. Preparation and characterization of in situ chitosan/polyethylene glycol fumarate/thymol hydrogel as an effective wound dressing. Mater. Sci. Eng. C 2017, 79, 66–75. [Google Scholar] [CrossRef] [PubMed]
- Mishra, S.K.; Mary, D.S.; Kannan, S. Copper incorporated microporous chitosan-polyethylene glycol hydrogels loaded with naproxen for effective drug release and anti-infection wound dressing. Int. J. Biol. Macromol. 2017, 95, 928–937. [Google Scholar] [CrossRef] [PubMed]
- Ding, L.; Shan, X.; Zhao, X.; Zha, H.; Chen, X.; Wang, J.; Cai, C.; Wang, X.; Li, G.; Hao, J.; et al. Spongy bilayer dressing composed of chitosan–Ag nanoparticles and chitosan–Bletilla striata polysaccharide for wound healing applications. Carbohydr. Polym. 2017, 157, 1538–1547. [Google Scholar] [CrossRef]
- Blažević, F.; Milekić, T.; Romić, M.D.; Juretić, M.; Pepić, I.; Filipović-Grčić, J.; Lovrić, J.; Hafner, A. Nanoparticle-mediated interplay of chitosan and melatonin for improved wound epithelialisation. Carbohydr. Polym. 2016, 146, 445–454. [Google Scholar] [CrossRef]
- Porporatto, C.; Bianco, I.D.; Riera, C.M.; Correa, S.G. Chitosan induces different l-arginine metabolic pathways in resting and inflammatory macrophages. Biochem. Biophys. Res. Commun. 2003, 304, 266–272. [Google Scholar] [CrossRef]
- Kean, T.; Thanou, M. Biodegradation, biodistribution and toxicity of chitosan. Adv. Drug Deliv. Rev. 2010, 62, 3–11. [Google Scholar] [CrossRef]
- Gu, B.K.; Park, S.J.; Kim, M.S.; Lee, Y.J.; Kim, J.-I.; Kim, C.-H. Gelatin blending and sonication of chitosan nanofiber mats produce synergistic effects on hemostatic functions. Int. J. Biol. Macromol. 2016, 82, 89–96. [Google Scholar] [CrossRef] [PubMed]
- Okamoto, Y.; Kawakami, K.; Miyatake, K.; Morimoto, M.; Shigemasa, Y.; Minami, S. Analgesic effects of chitin and chitosan. Carbohydr. Polym. 2002, 49, 249–252. [Google Scholar] [CrossRef]
- Golub, L.M.; Sorsa, T.; Lee, H.-M.; Ciancio, S.; Sorbi, D.; Ramamurthy, N.S.; Gruber, B.; Salo, T.; Konttinen, Y.T. Doxycycline inhibits neutrophil (PMN)-type matrix metalloproteinases in human adult periodontitis gingiva. J. Clin. Periodontol. 1995, 22, 100–109. [Google Scholar] [CrossRef] [PubMed]
- García, R.A.; Pantazatos, D.P.; Gessner, C.R.; Go, K.V.; Woods, V.L.; Villarreal, F.J. Molecular Interactions between Matrilysin and the Matrix Metalloproteinase Inhibitor Doxycycline Investigated by Deuterium Exchange Mass Spectrometry. Mol. Pharmacol. 2005, 67, 1128–1136. [Google Scholar] [CrossRef] [PubMed]
- Greenwald, R.A. Treatment of destructive arthritic disorders with MMP inhibitors. Potential role of tetracyclines. Ann. N. Y. Acad. Sci. 1994, 732, 181–198. [Google Scholar] [CrossRef]
- Aquino, R.P.; Auriemma, G.; Mencherini, T.; Russo, P.; Porta, A.; Adami, R.; Liparoti, S.; Porta, G.D.; Reverchon, E.; Del Gaudio, P. Design and production of gentamicin/dextrans microparticles by supercritical assisted atomisation for the treatment of wound bacterial infections. Int. J. Pharm. 2013, 440, 188–194. [Google Scholar] [CrossRef]
- Bowler, P.G.; Welsby, S.; Towers, V.; Booth, R.; Hogarth, A.; Rowlands, V.; Joseph, A.; Jones, S.A. Multidrug-resistant organisms, wounds and topical antimicrobial protection. Int. Wound J. 2012, 9, 387–396. [Google Scholar] [CrossRef]
- Cerciello, A.; Del Gaudio, P.; Granata, V.; Sala, M.; Aquino, R.P.; Russo, P. Synergistic effect of divalent cations in improving technological properties of cross-linked alginate beads. Int. J. Biol. Macromol. 2017, 101, 100–106. [Google Scholar] [CrossRef]
- Del Gaudio, P.; Amante, C.; Civale, R.; Bizzarro, V.; Petrella, A.; Pepe, G.; Campiglia, P.; Russo, P.; Aquino, R.P. In situ gelling alginate-pectin blend particles loaded with Ac2-26: A new weapon to improve wound care armamentarium. Carbohydr. Polym. 2020, 227, 115305. [Google Scholar] [CrossRef]
- Yoon, D.S.; Lee, Y.; Ryu, H.A.; Jang, Y.; Lee, K.-M.; Choi, Y.; Choi, W.J.; Lee, M.; Park, K.M.; Park, K.D.; et al. Cell recruiting chemokine-loaded sprayable gelatin hydrogel dressings for diabetic wound healing. Acta Biomater. 2016, 38, 59–68. [Google Scholar] [CrossRef]
- Del Gaudio, P.; Auriemma, G.; Russo, P.; Mencherini, T.; Campiglia, P.; Stigliani, M.; Aquino, R.P. Novel co-axial prilling technique for the development of core–shell particles as delayed drug delivery systems. Eur. J. Pharm. Biopharm. 2014, 87, 541–547. [Google Scholar] [CrossRef]
- De Falco, G.; Porta, A.; Petrone, A.M.; Del Gaudio, P.; El Hassanin, A.; Commodo, M.; Minutolo, P.; Squillace, A.; D’Anna, A. Antimicrobial activity of flame-synthesized nano-TiO2 coatings. Environ. Sci. Nano 2017, 4, 1095–1107. [Google Scholar] [CrossRef]
- Boukamp, P.; Petrussevska, R.T.; Breitkreutz, D.; Hornung, J.; Markham, A.; Fusenig, N.E. Normal keratinization in a spontaneously immortalized aneuploid human keratinocyte cell line. J. Cell Biol. 1988, 106, 761–771. [Google Scholar] [CrossRef] [Green Version]
- Toth, M.; Fridman, R. Assessment of gelatinases (MMP-2 and MMP-9 by gelatin zymography. In Metastasis Research Protocols; Springer: Berlin/Heidelberg, Germany, 2001; pp. 163–174. [Google Scholar] [CrossRef] [Green Version]
- Lawrie, G.; Keen, I.; Drew, B.; Chandler-Temple, A.; Rintoul, L.; Fredericks, P.; Grøndahl, L. Interactions between Alginate and Chitosan Biopolymers Characterized Using FTIR and XPS. Biomacromolecules 2007, 8, 2533–2541. [Google Scholar] [CrossRef]
- Simsek-Ege, F.A.; Bond, G.M.; Stringer, J. Polyelectrolyte complex formation between alginate and chitosan as a function of pH. J. Appl. Polym. Sci. 2003, 88, 346–351. [Google Scholar] [CrossRef]
- Lai, H.L.; Abu’Khalil, A.; Craig, D.Q.M. The preparation and characterisation of drug-loaded alginate and chitosan sponges. Int. J. Pharm. 2003, 251, 175–181. [Google Scholar] [CrossRef]
- Hashad, R.A.; Ishak, R.A.H.; Fahmy, S.; Mansour, S.; Geneidi, A.S. Chitosan-tripolyphosphate nanoparticles: Optimization of formulation parameters for improving process yield at a novel pH using artificial neural networks. Int. J. Biol. Macromol. 2016, 86, 50–58. [Google Scholar] [CrossRef] [PubMed]
- Alsharabasy, A.M.; Moghannem, S.A.; El-Mazny, W.N. Physical preparation of alginate/chitosan polyelectrolyte complexes for biomedical applications. J. Biomater. Appl. 2016, 30, 1071–1079. [Google Scholar] [CrossRef]
- Jaya, S.; Durance, T.D.; Wang, R. Effect of alginate-pectin composition on drug release characteristics of microcapsules. J. Microencapsul. 2009, 26, 143–153. [Google Scholar] [CrossRef] [PubMed]
- Dresvyanina, E.N.; Grebennikov, S.F.; Elokhovskii, V.Y.; Dobrovolskaya, I.P.; Ivan’kova, E.M.; Yudin, V.E.; Heppe, K.; Morganti, P. Thermodynamics of interaction between water and the composite films based on chitosan and chitin nanofibrils. Carbohydr. Polym. 2020, 245, 116552. [Google Scholar] [CrossRef] [PubMed]
- Silva, H.F.; Lima, K.M.; Cardoso, M.B.; Oliveira, J.F.; Melo, M.C.; Sant’Anna, C.; Eugênio, M.; Gasparotto, L.H. Doxycycline conjugated with polyvinylpyrrolidone-encapsulated silver nanoparticles: A polymer’s malevolent touch against Escherichia coli. RSC Adv. 2015, 5, 66886–66893. [Google Scholar] [CrossRef]
- Cover, N.F.; Lai-Yuen, S.; Parsons, A.K.; Kumar, A. Synergetic effects of doxycycline-loaded chitosan nanoparticles for improving drug delivery and efficacy. Int. J. Nanomed. 2012, 7, 2411–2419. [Google Scholar] [CrossRef] [Green Version]
- Serra, R.; Grande, R.; Butrico, L.; Rossi, A.; Settimio, U.F.; Caroleo, B.; Amato, B.; Gallelli, L.; de Franciscis, S. Chronic wound infections: The role of Pseudomonas aeruginosa and Staphylococcus aureus. Expert Rev. Anti Infect. Ther. 2015, 13, 605–613. [Google Scholar] [CrossRef]
- Tao, Y.; Qian, L.-H.; Xie, J. Effect of chitosan on membrane permeability and cell morphology of Pseudomonas aeruginosa and Staphyloccocus aureus. Carbohydr. Polym. 2011, 86, 969–974. [Google Scholar] [CrossRef]
- Ashcroft, G.S.; Jeong, M.-J.; Ashworth, J.J.; Hardman, M.; Jin, W.; Moutsopoulos, N.; Wild, T.; McCartney-Francis, N.; Sim, D.; McGrady, G.; et al. Tumor necrosis factor-alpha (TNF-α) is a therapeutic target for impaired cutaneous wound healing. Wound Repair Regen. 2012, 20, 38–49. [Google Scholar] [CrossRef] [Green Version]
- Lin, Z.Q.; Kondo, T.; Ishida, Y.; Takayasu, T.; Mukaida, N. Essential involvement of IL-6 in the skin wound-healing process as evidenced by delayed wound healing in IL-6-deficient mice. J. Leukoc. Biol. 2003, 73, 713–721. [Google Scholar] [CrossRef] [PubMed]
- Park, C.J.; Gabrielson, N.P.; Pack, D.W.; Jamison, R.D.; Wagoner Johnson, A.J. The effect of chitosan on the migration of neutrophil-like HL60 cells, mediated by IL-8. Biomaterials 2009, 30, 436–444. [Google Scholar] [CrossRef]
- Jiang, W.G.; Sanders, A.J.; Ruge, F.; Harding, K.G. Influence of interleukin-8 (IL-8) and IL-8 receptors on the migration of human keratinocytes, the role of PLC-γ and potential clinical implications. Exp. Med. 2012, 3, 231–236. [Google Scholar] [CrossRef] [PubMed] [Green Version]
- Caley, M.P.; Martins, V.L.C.; O’Toole, E.A. Metalloproteinases and Wound Healing. Adv. Wound Care (New Rochelle) 2015, 4, 225–234. [Google Scholar] [CrossRef] [Green Version]
- Tarlton, J.F.; Vickery, C.J.; Leaper, D.J.; Bailey, A.J. Postsurgical wound progression monitored by temporal changes in the expression of matrix metalloproteinase-9. Br. J. Dermatol. 1997, 137, 506–516. [Google Scholar] [CrossRef] [PubMed]
- Lee, H.M.; Ciancio, S.G.; Tuter, G.; Ryan, M.E.; Komaroff, E.; Golub, L.M. Subantimicrobial dose doxycycline efficacy as a matrix metalloproteinase inhibitor in chronic periodontitis patients is enhanced when combined with a non-steroidal anti-inflammatory drug. J. Periodontol. 2004, 75, 453–463. [Google Scholar] [CrossRef]
- Castro, M.M.; Tanus-Santos, J.E.; Gerlach, R.F. Matrix metalloproteinases: Targets for doxycycline to prevent the vascular alterations of hypertension. Pharmacol. Res. 2011, 64, 567–572. [Google Scholar] [CrossRef] [PubMed] [Green Version]
- Lee, H.; Park, J.W.; Kim, S.P.; Lo, E.H.; Lee, S.R. Doxycycline inhibits matrix metalloproteinase-9 and laminin degradation after transient global cerebral ischemia. Neurobiol. Dis. 2009, 34, 189–198. [Google Scholar] [CrossRef] [PubMed]
- Ryan, M.E.; Usman, A.; Ramamurthy, N.S.; Golub, L.M.; Greenwald, R.A. Excessive matrix metalloproteinase activity in diabetes: Inhibition by tetracycline analogues with zinc reactivity. Curr. Med. Chem. 2001, 8, 305–316. [Google Scholar] [CrossRef]
- Uitto, V.J.; Firth, J.D.; Nip, L.; Golub, L.M. Doxycycline and chemically modified tetracyclines inhibit gelatinase A (MMP-2) gene expression in human skin keratinocytes. Ann. N. Y. Acad. Sci. 1994, 732, 140–151. [Google Scholar] [CrossRef] [PubMed]

| Sample Code | Alginate/Pectin/Chitosan Ratio | Doxycycline (w/w) | Yield (%) | Drug Content (%) | E.E. (%) | Mean Diameter (µm) |
|---|---|---|---|---|---|---|
| AP-11 | 1:1 | - | 63 | - | - | 2.07 ± 0.08 |
| AP-31 | 3:1 | 65 | 2.16 ± 0.11 | |||
| AP-13 | 1:3 | 61 | 2.85 ± 0.49 | |||
| AP-11-1D | 1:1 | 1.0% | 62 | 0.70 | 69 | 2.11 ± 0.12 |
| AP-11-2D | 1:1 | 2.0% | 62 | 1.41 | 70 | 2.13 ± 0.15 |
| AP-31-2D | 3:1 | 64 | 1.33 | 66 | 2.21 ± 0.13 | |
| AP-13-2D | 1:3 | 66 | 1.38 | 69 | 2.74 ± 0.43 | |
| APC-111 | 1:1:1 | - | 60 | - | - | 3.24 ± 0.13 |
| APC-113 | 1:1:3 | 72 | 2.75 ± 0.10 | |||
| APC-117 | 1:1:7 | 73 | 2.58 ± 0.04 | |||
| APC-111-1D | 1:1:1 | 1.0% | 62 | 0.69 | 69 | 3.25 ± 0.08 |
| APC-113-1D | 1:1:3 | 68 | 0.72 | 72 | 2.78 ± 0.09 | |
| APC-117-1D | 1:1:7 | 70 | 0.78 | 78 | 2.24 ± 0.13 | |
| APC-111-2D | 1:1:1 | 2.0% | 62 | 1.33 | 67 | 3.59 ± 0.09 |
| APC-113-2D | 1:1:3 | 71 | 1.41 | 71 | 2.69 ± 0.12 | |
| APC-117-2D | 1:1:7 | 74 | 1.56 | 78 | 2.42 ± 0.11 |
Publisher’s Note: MDPI stays neutral with regard to jurisdictional claims in published maps and institutional affiliations. |
© 2021 by the authors. Licensee MDPI, Basel, Switzerland. This article is an open access article distributed under the terms and conditions of the Creative Commons Attribution (CC BY) license (https://creativecommons.org/licenses/by/4.0/).
Share and Cite
Amante, C.; Esposito, T.; Del Gaudio, P.; Di Sarno, V.; Porta, A.; Tosco, A.; Russo, P.; Nicolais, L.; Aquino, R.P. A Novel Three-Polysaccharide Blend In Situ Gelling Powder for Wound Healing Applications. Pharmaceutics 2021, 13, 1680. https://doi.org/10.3390/pharmaceutics13101680
Amante C, Esposito T, Del Gaudio P, Di Sarno V, Porta A, Tosco A, Russo P, Nicolais L, Aquino RP. A Novel Three-Polysaccharide Blend In Situ Gelling Powder for Wound Healing Applications. Pharmaceutics. 2021; 13(10):1680. https://doi.org/10.3390/pharmaceutics13101680
Chicago/Turabian StyleAmante, Chiara, Tiziana Esposito, Pasquale Del Gaudio, Veronica Di Sarno, Amalia Porta, Alessandra Tosco, Paola Russo, Luigi Nicolais, and Rita P. Aquino. 2021. "A Novel Three-Polysaccharide Blend In Situ Gelling Powder for Wound Healing Applications" Pharmaceutics 13, no. 10: 1680. https://doi.org/10.3390/pharmaceutics13101680
APA StyleAmante, C., Esposito, T., Del Gaudio, P., Di Sarno, V., Porta, A., Tosco, A., Russo, P., Nicolais, L., & Aquino, R. P. (2021). A Novel Three-Polysaccharide Blend In Situ Gelling Powder for Wound Healing Applications. Pharmaceutics, 13(10), 1680. https://doi.org/10.3390/pharmaceutics13101680

